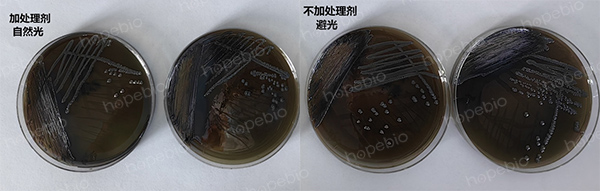
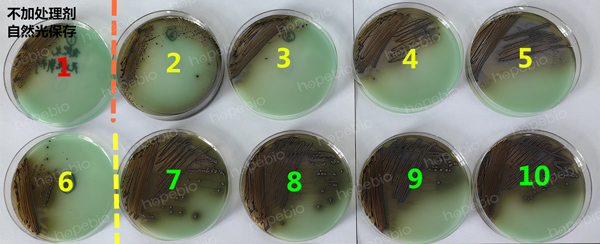
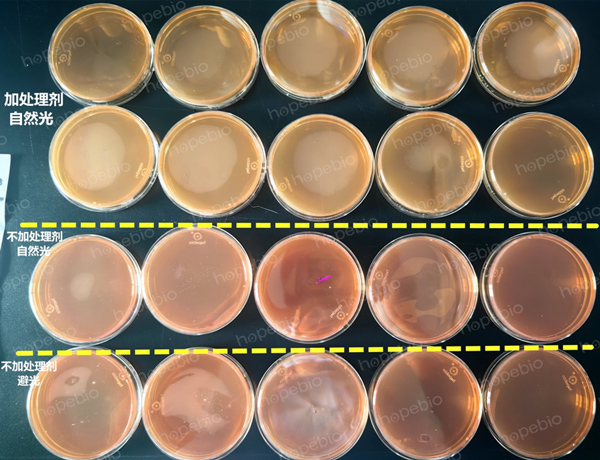
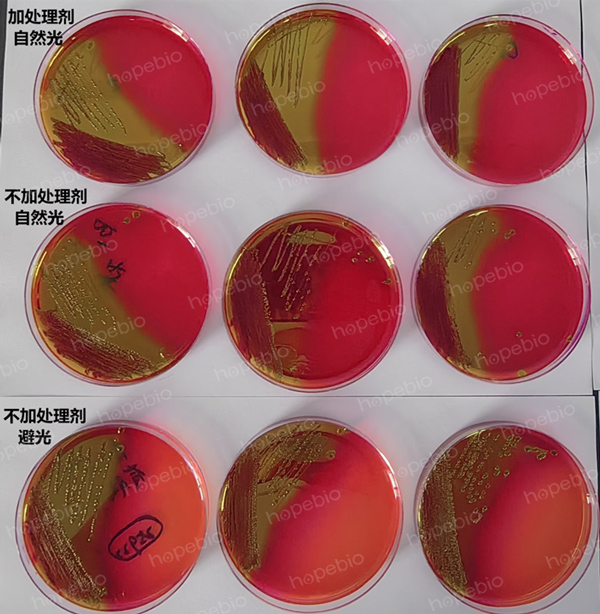

海博微信公众号
海博微信公众号
 海博天猫旗舰店
海博天猫旗舰店


 海博微信公众号
海博微信公众号
 海博天猫旗舰店
海博天猫旗舰店




一、问题
亚硫酸铋(BS)琼脂,是《GB4789.4-2024 食品安全国家标准 食品微生物学检验 沙门氏菌检验》中用到的分离培养基,平板原本为玉白色,放置几天后,平板变绿,影响使用。
品红亚硫酸钠培养基,是《GB 8538-2022 食品安全国家标准 饮用天然矿泉水检验方法》中检验大肠菌群用到的培养基,其平板原本为淡橙色,放置几天后,平板变为橙红色,影响使用。
二、试验方案
对两种培养基平板均采用纸塑袋外面加/不加处理剂和避光、自然光结合的方式进行试验(如表1)。
表1 两种培养基的保存方式
|
培养基 |
组别 |
处理剂 |
光照 |
抽真空 |
冷藏 |
|
BS琼脂 |
第一组 |
√ |
自然光 |
× |
√ |
|
第二组 |
× |
避光 |
× |
√ |
|
|
第三组 |
× |
自然光 |
√ |
√ |
|
|
品红亚硫酸钠琼脂 |
第一组 |
√ |
自然光 |
√ |
√ |
|
第二组 |
× |
自然光 |
× |
√ |
|
|
第三组 |
× |
避光 |
× |
√ |
三、试验结果
(1)BS琼脂平板,试验一个月后,第一组、第二组不变色,第三组全部变绿,且最上面的平板绿的程度更深,最下面的平板变绿的程度最浅(如图1)。即加处理剂或避光保存,都能保证一个月内不变色,两种处理方式效果相同。既不加处理剂又不避光的情况下,平板很容易变绿。

图1 不同方式处理保存的BS琼脂平板颜色变化情况
将鼠伤寒沙门氏菌ATCC 14028划线至各组平板上,36℃培养24h后菌种的的生长状态显示:只要平板颜色正常,接菌后就能正常生长,且菌落特征明显(第一组、第二组);变绿的平板上,菌种生长情况差(第三组),绿的程度越深,生长越差(第三组,自上而下,最上面的平板只有1区生长,中间几块平板可以2区有单菌落,最下面几块平板可3区生长,但整体都不如第一组和第二组平板上菌落特征明显)。(如图2)

图2 不同处理方式保存的BS琼脂平板上质控菌的生长情况
(2)品红亚硫酸钠琼脂
一个月后,试验结果如下:第一组颜色不变,一整摞自上而下颜色稳定;第二组、第三组均变红(如图3)。即对于品红亚硫酸钠来说,加处理剂是最有效的方法,无处理剂的情况下,无论自然光还是避光保存,都不能保证颜色稳定。
图3 不同处理方式保存的品红亚硫酸钠琼脂平板颜色变化情况
将大肠埃希氏菌ATCC 25922接种在各组平板上,36℃培养24 h后的生长状态显示,平板颜色稍微变化,菌落生长情况影响不大。(如图4)
图4 不同处理方式保存的品红亚硫酸钠琼脂平板上质控菌的生长情况
四、结论与建议
两种培养基平板虽然都存在颜色变化的问题,但解决的方式不尽相同。实际生产中,不同的培养基应根据其特性进行相应的有效处理,保证平板在使用前颜色不发生明显变化。有些培养基颜色变化不影响使用,有些会影响使用,要根据情况判断取舍。
即用型培养基平板给实验室工作带来了很大的便利,用户在收货后,要正确保存,尽快使用,最大程度保证平板颜色的稳定。
我公司生产的两种即用型平板展示如下(图5),详情请参考:亚硫酸铋琼脂平板(9cm),品红亚硫酸钠琼脂平板(9cm)。


图5 两种商品化的即用型培养基平板
相关产品:
注:本文属海博生物原创,未经允许不得转载。
下一篇:培养基煮沸灭菌的操作要领
| 相关文章: | ||



